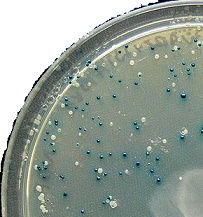

Selektion og screening
Efter en gensplejsning vil kun et fåtal af cellerne faktisk være korrekt gensplejset, men dem har man værktøjer til at udvælge blandt alle de andre.
Selektion er en udvælgelse af bestemte genetisk forandrede celler (mutanter), fx efter en gensplejsning. I gensplejsning vil typisk kun en lille andel af cellerne faktisk blive gensplejset som ønsket. For at undgå at skulle teste en masse forkerte celler, kan man bruge selektion.

Figur 1. Selektion med antibiotikum for at udvælge de gensplejsede celler. Kun de gensplejsede celler bærer selektionsgenet, som giver dem resistens overfor antibiotikumet. På vækstpladen med antibiotikum vil kun disse celler gro frem. Uden antibiotikum på pladen ville celler, der ikke blev gensplejset, også kunne gro frem.
Ved selektion skaber man et miljø for cellerne, hvor kun celler med et bestemt selektionsgen kan vokse, fx et resistensgen til antibiotika. Dette selektions-gen sætter man ind sammen med det nye gen under gensplejsningen. Selektions-genet bliver på den måde en markør for, at gensplejsningen er lykkedes. Dette skyldes, at kun de rigtigt gensplejsede celler vil kunne overleve sammen med det valgte antibiotikum. Princippet er en positiv selektion, da de interessante celler, der selekteres for, netop overlever. (se figur 1)
Selektionsformer
Antibiotikaresistens er en populær selektionsform. Den kan bruges fx i bakterier, der er følsomme over for et antibiotikum. Man skal kende et selektionsgen for resistens, der fjerner denne følsomhed. Ampicillin og kanamycin er eksempler på forskellige antibiotika, man genetisk kan give resistens overfor. Kanamycin virker dræbende for bakterier ved en mekanisme, der er udbredt for antibiotika. Stoffet binder sig til et område af ribosomerne, så de forstyrres kraftigt i proteinsyntesen, og bakterien dør.
Resistensgenet over for kanamycin virker ved at kode for et enzym i cellerne, der inaktiverer kanamycinen.
Det kan anses som kritisabelt at indsætte resistens-gener i organismer, der sættes ud i naturen, som fx GM-afgrøder. Generne kan i teorien spredes til andre, vilde planter, og man kan derved fx frygte, at antibiotikaresistensen spreder sig til farligere organismer.
Auxotrofi er et andet princip, som også bruges til selektion. En organisme, der ikke kan klare sig uden at få tilført et bestemt næringsstof, siges at være auxotrof overfor det. Når man gensplejser, kan man selektere de rigtige celler ved at give et selektionsgen med, der får disse celler til selv at danne næringsstoffet, så de kan overleve uden. Når man ikke tilsætter næringsstoffet, vil kun de rigtige celler overleve – de er altså selekteret.
Næringsstoffet kan fx være et bestemt nukleotid eller aminosyre, som fx aminosyren histidin. Organismen skal starte som histidin-auxotrof, så hvis den ikke er det, må man slette et af de histidin-ansvarlige gener, som fx HIS3-genet i bagegær (S. cerevisiae). Den histidin-auxotrofe organisme kan dermed bruges til selektionen med et HIS3-selektionsgen.
Screening
Screening er en metode til at kunne genkende bestemte genetiske mutanter, fx efter en gensplejsning, hvor man vil kunne udvælge en celle, der er korrekt gensplejset. I modsætning til selektion, hvor kun de rigtigt gensplejsede mutanter vil gro frem, kan screening foregå ved at de transformerede celler fx får en anderledes farve eller udskiller et farvet stof blandt de andre celler. Disse kolonier af celler udvælger man så selv fra vækstpladen.
Et udbredt screeningsgen er lacZ der stammer fra E. coli og koder for enzymet β-galactosidase. Cellekolonier, man får til at udtrykke lacZ-genet, vil få en blålig farve, når de vokser på et næringsmedium tilsat stoffet X-gal (5-brom-4-chlor-3-indolyl-β-D-galactosid), og de giver sig derfor tydeligt til kende (figur 2).
Figur 2. Bakteriekolonier i screening med screeningsgenet lacZ fremstår blå på medium med X-gal. Foto: Navaho (GFD licens v. 1.2)
Screening for spændende stoffer
Screening bruges også til at finde mikroorganismer, der producerer interessante stoffer, som fx antibiotika eller enzymer. Her kan tusindvis af fundne kandidater vurderes for at se, om nogle af dem producerer nogle interessante stoffer.